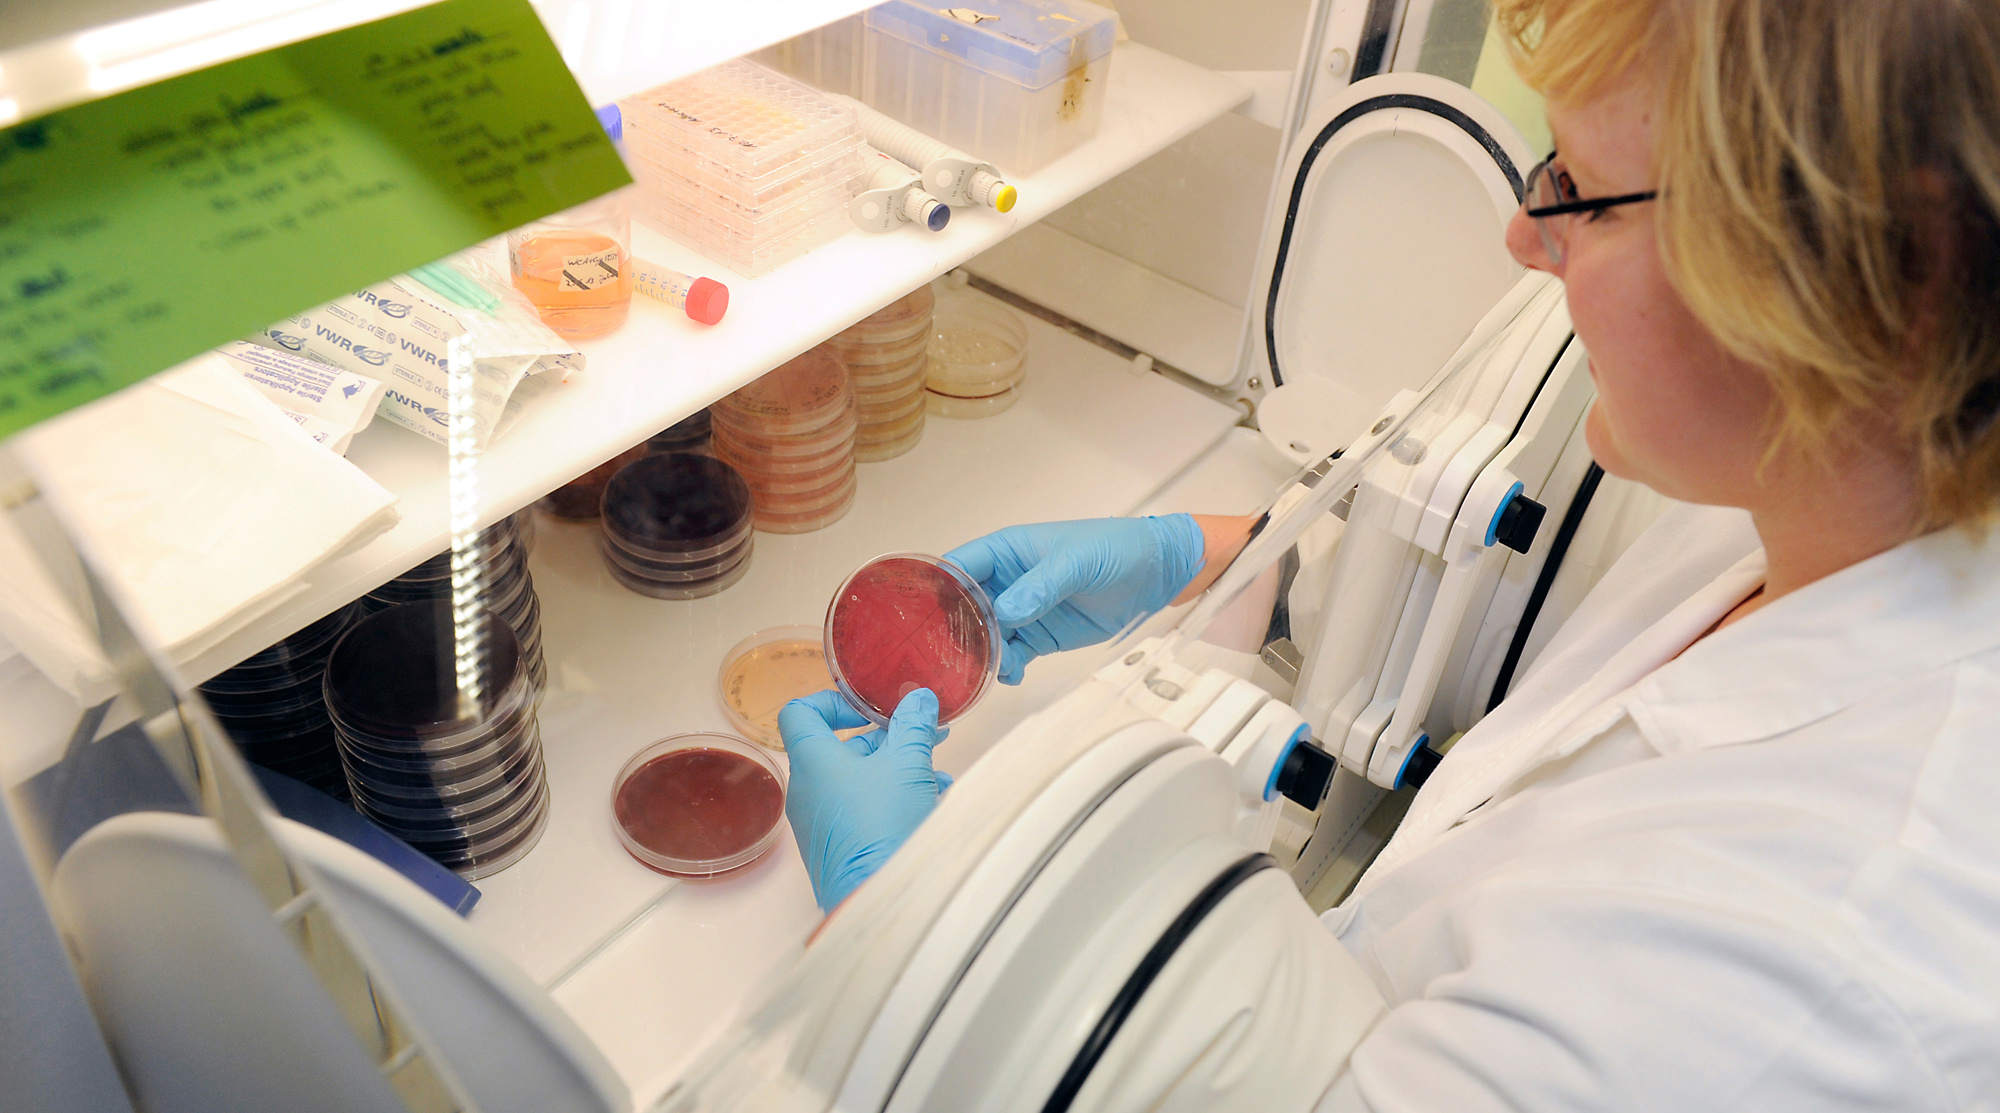
An anaerobic chamber for growing fastidious bacterial species from the intestine.

Get them growing! A public catalog of cultured bacterial strains from the mouse intestine
Published in Microbiology
Bacteria colonizing the intestine of mammals influence host physiology and the onset and maintenance of diseases. This is nowadays textbook knowledge thanks to intensive research in the field of gut microbial ecology and microbe-host interactions, with a particular rebound of interest in the last fifteen years primarily due to breakthrough in sequencing technologies. However, the resolution of these molecular techniques is utterly dependent on the quality of databases used to interpret datasets. This is where cultivating bacteria is valuable: it allows discovery of novel taxa and eventually the implementation of databases if detailed genetic work is performed.
Mice are the most widely used animals in research. In the field of microbe-host interactions, germfree mice (i.e. mice that live in a sterile environment and can be colonized with microorganisms of choice) are particularly useful, for instance to assess the effects of colonization on the development of diseases. Moreover, intestinal colonization can be host-specific (the occurrence of specific bacteria is different between human and mice for instance). The problem is that little information has been available on the diversity and identity of bacterial species in the mouse gut: many of the sequences obtained by molecular studies cannot be annotated, and reference bacterial strains have not been available.
Ten years ago, when I was hired at TU Munich as microbiologist in a lab dealing mostly with immunology, I started doing what I could do best: isolating and identifying bacteria using intestinal samples from some of the mouse models widely used around me. I focused primarily on anaerobic bacteria, which cannot grow in normal air and have to be handled in chambers with an inner atmosphere deprived of oxygen.
Isolating gut
bacteria is fascinating. You are always full of hopes when designing new
experimental conditions, the ones that may eventually get you to the species
you have been looking for. And it is always very exciting to look at these
little cells under the microscope, see how they look like, and eventually get a
glimpse of what they are and possibly what they can do by sequencing their
genomes or some specific phylogenetic marker genes. It can be frustrating too
though: when you obtain for the thousandth time usual suspects such as Escherichia coli or lactobacilli; it can
be time consuming (several weeks or even months can be necessary to subculture
fastidious anaerobes and make sure that cultures are pure); and most of all, it
used not to be very much rewarding to isolate and describe bacteria in the current
molecular era of microbial ecology.
Over the years isolating and describing bacteria, we have realized that the community of scientists would greatly benefit from a common resource cataloging mouse gut bacterial strains and making them available for research purposes. Things put into place slowly. The pool of strains we obtained was growing. The field was ready to acknowledge that culture methods had been neglected over the last decades. Involvement of the internationally recognized bioresource DSMZ (German Collection of Microorganisms and Cell Cultures) was a key element in the project. Indeed, isolating bacteria from the mouse intestine was carried out in the 1970’s already, but strains got lost over the years. Hence, besides providing novel bacterial diversity, functionality, and host-specificity of gut colonization, the major goal we followed was to help as many researchers as possible by establishing a public resource. The mouse intestinal Bacterial Collection (miBC) was born, and it will hopefully be useful to many (www.dsmz.de/miBC). Anybody who, like us, has fun isolating microorganisms from the mouse intestine and wants to contribute to the extension of this unique resource is welcome to get in touch with us.
Thomas Clavel, PhD
Technical University of Munich, ZIEL Institute for Food and Health, Germany
Please sign in or register for FREE
If you are a registered user on Research Communities by Springer Nature, please sign in